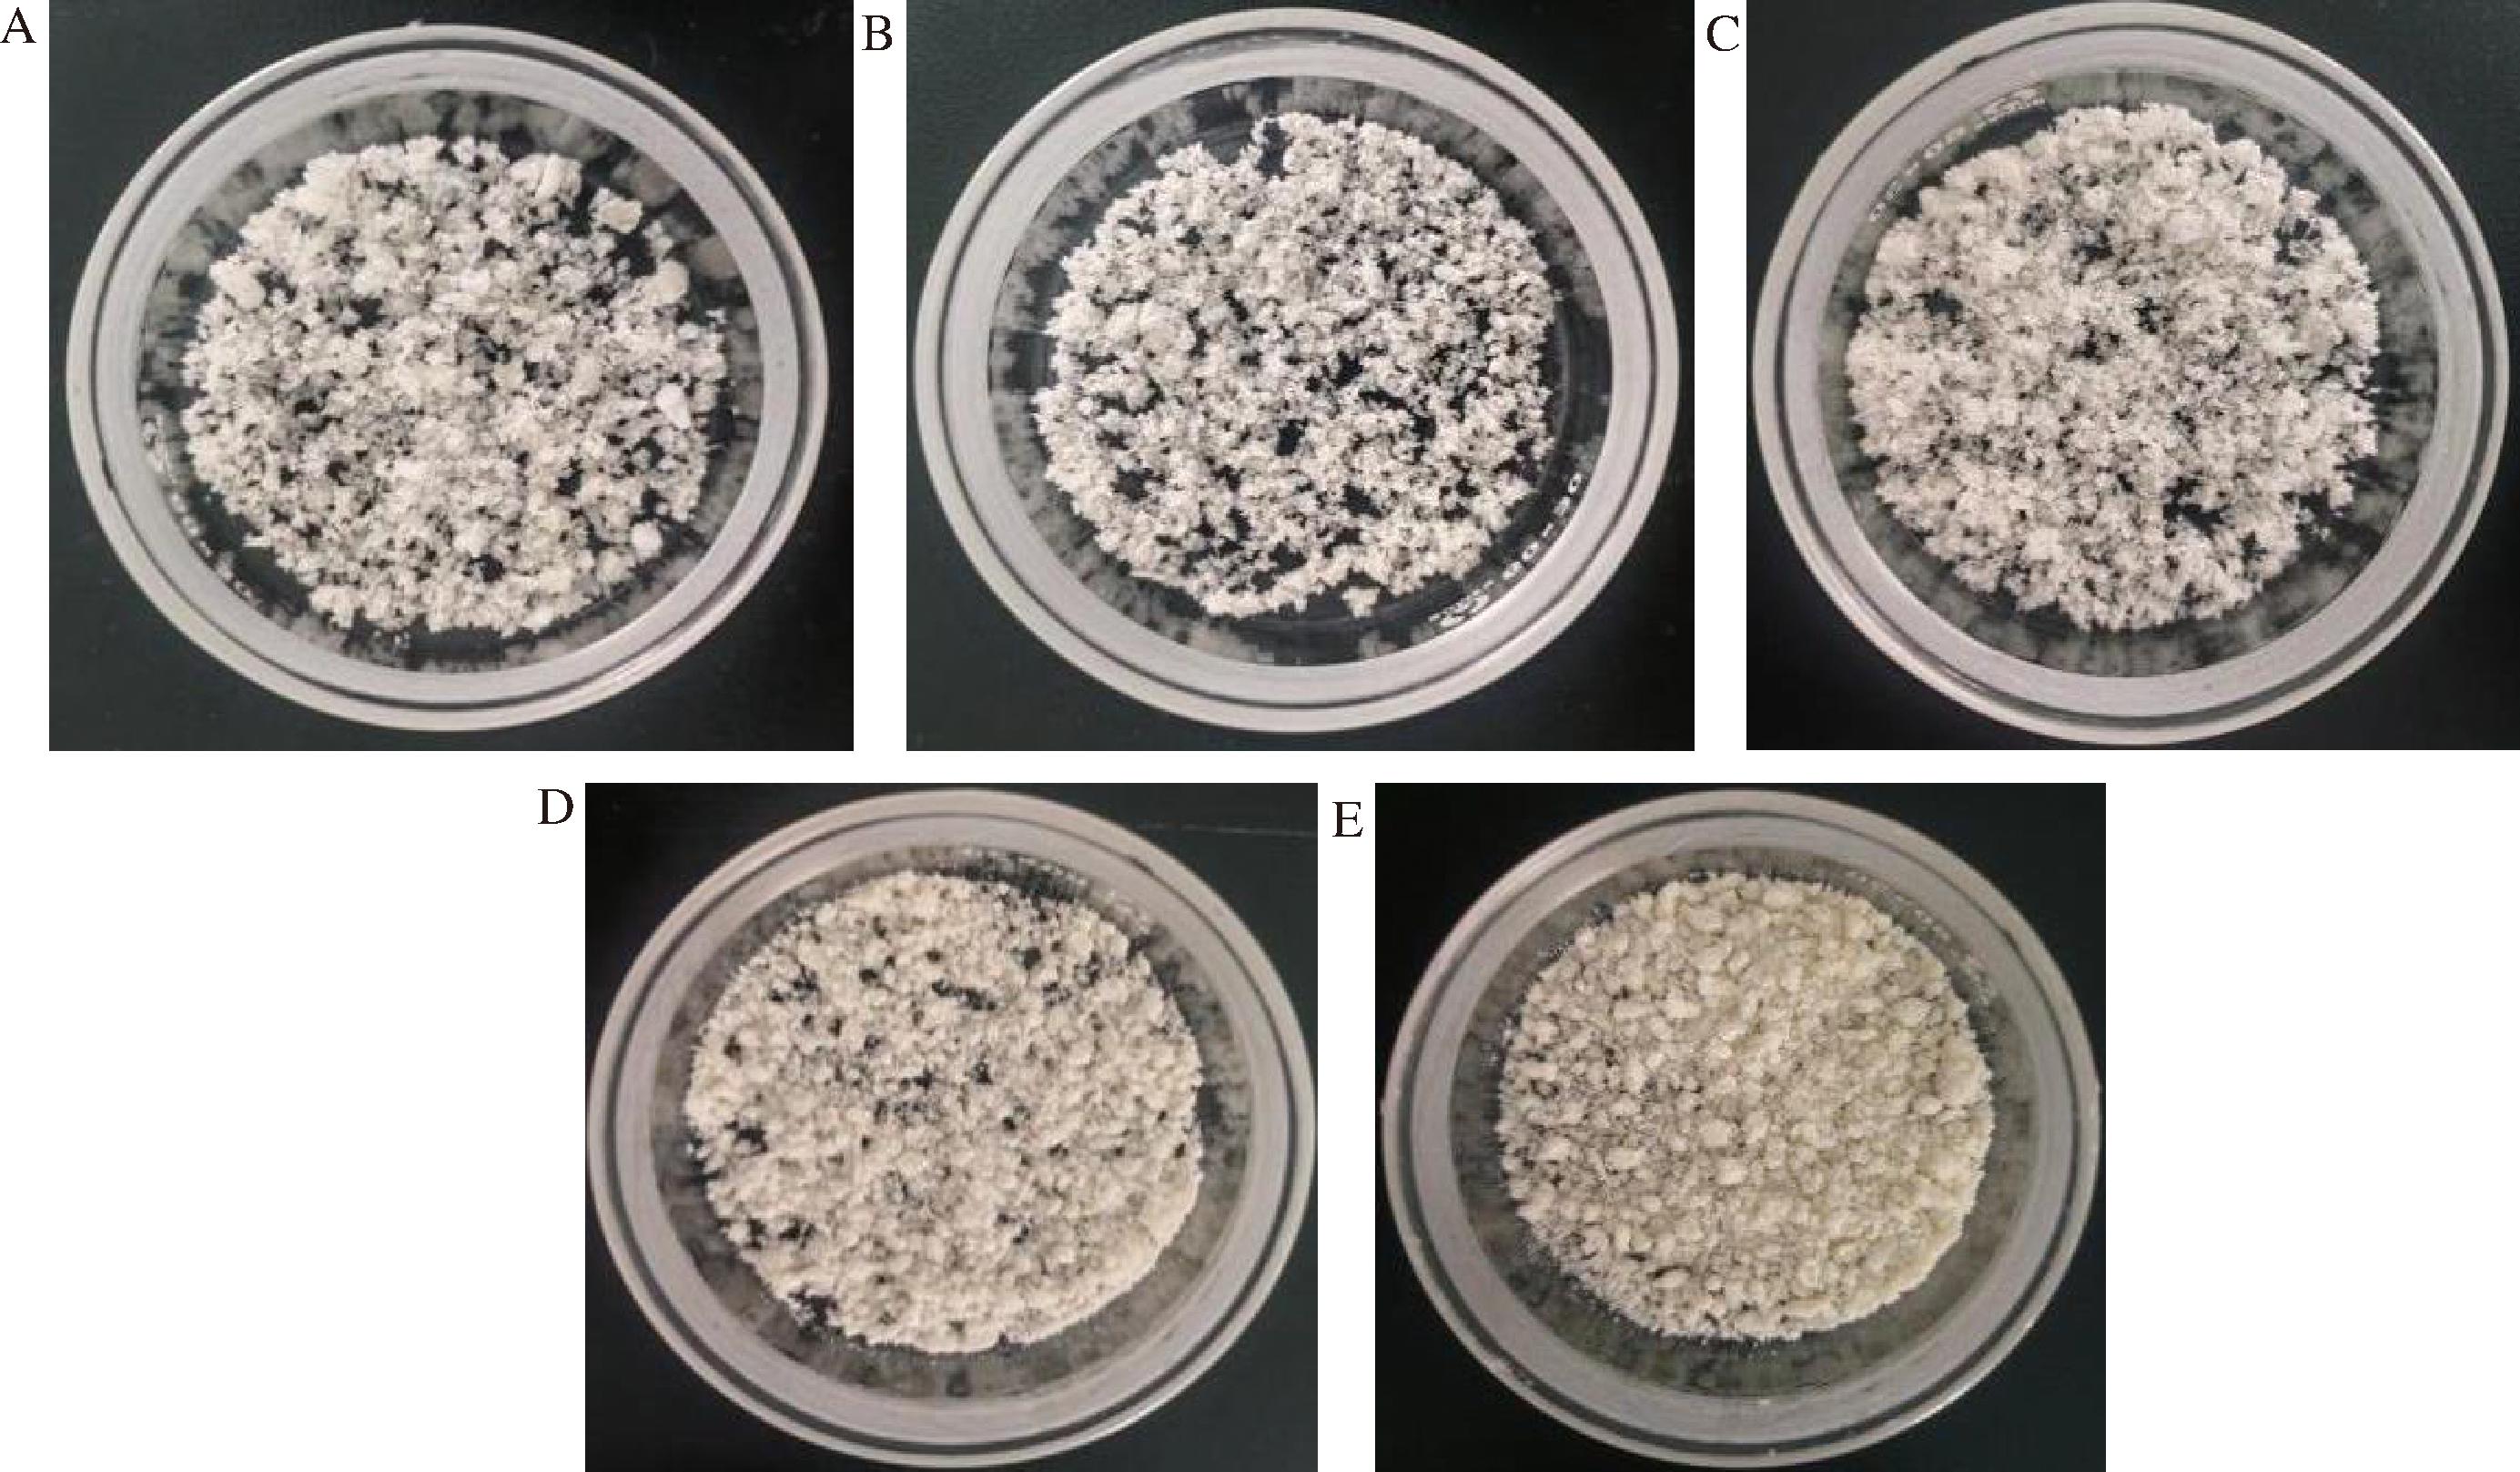

文冠果(Xanthoceras sorbifolium Bunge)为无患子科文冠果属,是我国特有的木本油料植物[1]。文冠果原产于中国北方干旱寒冷地区,在宁夏、甘肃、辽宁、内蒙古、河南等地均有种植,尤其甘肃地理位置特殊,气候类型丰富多样,非常适宜种植文冠果树种[2]。研究表明,文冠果浑身是宝,叶、籽壳、种壳和种仁等各部位富含氨基酸、芦丁、三萜皂苷和黄酮类等活性化合物,营养价值和药用价值极为丰富。其中,文冠果种仁中的油脂含量高达60%以上,文冠果油中的不饱和脂肪酸比例高达95%以上[3],饱和脂肪酸、单不饱和脂肪酸和多不饱和脂肪酸三者比例接近食用油脂肪酸的合理配比要求,是人体摄入亚油酸的优质来源。文冠果油主要含有棕榈酸、硬脂酸、油酸、亚油酸和亚麻酸,以及少量十四烷酸、棕酮油酸及二十烷酸等20种脂肪酸,其中亚油酸含量约为41%,油酸含量约为30%。尤其是,文冠果油中的神经酸含量约为3.0%~3.5%,具有改善记忆、修复大脑神经信息传递通道等功效,对预防和治疗脑神经衰弱和阿尔兹海默症具有显著效果[4]。然而,由于不饱和脂肪酸容易氧化产生羟基自由基并引发连锁反应,导致文冠果油酸败进而降低营养价值和感官品质;另一方面,由于文冠果油中甘油三酯结构和组成成分的影响,其水溶性和稳定性相对较差,使其在食品工业中的应用受到限制。
微胶囊技术将目的物用各种天然或合成的高分子化合物完全包覆起来,而对目的物原有化学性质无损伤,通过某些外部刺激或缓释作用使目的物的功能再次在外部呈现出来,或者依靠囊壁的屏蔽作用起到保护芯材的作用。微胶囊技术不仅具有良好的有效载荷和热阻能力,保护生物活性物质免受不良环境影响[5],还能实现活性物质的缓慢释放效果,提高文冠果油的稳定性[6]。微胶囊常见的制备方法包括喷雾干燥法和冷冻干燥法。冷冻干燥技术通过在真空环境中去除冷冻状态下的水分,能有效防止热敏感物质的氧化和化学变化,保留其原始的物理化学特性及感官品质,因而被视为制备高质量微胶囊产品的理想方法。微胶囊制备常见的壁材主要有麦芽糊精(maltodextrin,MD)、大豆分离蛋白(soy protein isolate,SPI)和阿拉伯胶(acacia senegal,AS)等高分子物质。MD包埋效率高、氧化稳定性好,通常与阿拉伯胶等其他物质结合[7]。SPI富含必需氨基酸,属于优质蛋白,且含量丰富,是更安全的包埋运输体系。AS是一种多功能的生物聚合物,具有良好的溶解性、乳化性和保留挥发性物质的能力[8]。CALVO等[9]通过冷冻干燥法制备的微胶囊能阻止核桃油氧化酸败,且保持了核桃油的特有风味。BRILLIANA等[10]用肉桂皮精油微胶囊处理牛肉等食材后进行贮藏,可有效抑制微生物生长和脂质氧化。ZHU等[11]研究发现添加麦芽糊精可改善大豆油微胶囊在常温贮存中的吸湿性、包埋率和抗氧化活性。可见,微胶囊技术有助于提高油脂活性物质的水溶性和稳定性。
基于此,本文采用冷冻干燥法,以MD、SPI和AS为壁材,文冠果油为芯材,从微胶囊的形态学特性、包埋效率、包封状态、理化性能和贮存稳定性等角度,探讨不同壁材组成对文冠果油微胶囊特性效果的影响。在此基础上,利用电子显微镜和共聚焦激光扫描显微镜(confocal laser scanning microscope,CLSM)光谱观察微胶囊形貌特征,进一步表征评价壁材组成对微胶囊微观结构的影响。
1 材料与方法
1.1 材料与试剂
文冠果种仁油(文冠果油)由位于“中国文冠果之乡”靖远县的甘肃茂群天运文冠果开发有限责任公司提供;阿拉伯胶、麦芽糊精、大豆分离蛋白、大豆卵磷脂等,河南万邦化工科技有限公司,均为食品级。
1.2 仪器与设备
APRH破碎乳化机,扬州艾普威尔自动化设备有限公司;10N-50A冷冻干燥机,上海比朗仪器制造有限公司;RE52-99旋转蒸发仪,上海亚荣生化仪器厂;K9840 SH220F凯式定氮仪,浙江赛德仪器设备有限公司;NCF950共聚焦激光扫描显微镜,武汉菲谱光电技术有限公司;SN-TGA140热重分析仪,深圳市三莉科技有限公司;JV-DX X-射线衍射仪(X-ray diffraction,XRD),德国布鲁克公司。
1.3 实验方法
1.3.1 文冠果种仁油微胶囊的制备
1.3.1.1 AS-MD制备微胶囊
选用AS-MD作为壁材,两者质量比设定为1∶1、1∶2和1∶3,以0.1 mg/mL的浓度溶解,按照设定比例称取不同质量AS和MD,50 ℃溶解得到壁材溶液,然后4 ℃溶胀12 h。按照芯壁比为1∶5加入一定量文冠果油,10 000 r/min高速均质10 min后进行真空冷冻干燥,得到3组不同配方的AS-MD组合微胶囊。
1.3.1.2 SPI-MD制备微胶囊
选用SPI-MD作为壁材,两者质量比设为3∶1和3∶2,以0.1 mg/mL的浓度溶解。设定壁材含量为83%,芯材含量15%,大豆卵磷脂作为乳化剂(含量2%)。按照设定比例称取一定质量的SPI、MD和大豆卵磷脂,70 ℃溶解SPI和MD,50 ℃溶解文冠果油和大豆卵磷脂,将壁材溶液和芯材溶液混合后搅拌均质10 min,真空冷冻干燥得到2组不同配方的SPI-MD组合微胶囊。
1.3.2 文冠果油微胶囊的测定指标与方法
1.3.2.1 感官评价
参考QB/T 4791—2015《植脂末》中的感官评价方法。称取10 g文冠果油微胶囊,置于亮处,观察其组织形态及色泽,并取5 g微胶囊用100 mL 80 ℃蒸馏水溶解,嗅其气味。
1.3.2.2 包埋率
参考QB/T 4791—2015《植脂末》中的表面油脂测定方法进行测试。称取样品8 g(G)加入石油醚中,充分振摇后将滤液过滤至已恒重的圆底烧瓶中(W1),滤渣转入原锥形瓶中,石油醚振摇提取2次,滤液合并至圆底烧瓶。减压旋转蒸发15 min后45 ℃烘干至恒重,称量圆底烧瓶及表面油脂总质量(W2),表面油脂(X)计算如公式(1)所示。
(1)
以初始添加的文冠果油质量为总油质量(Y),包埋率计算如公式(2)所示[12]。
包埋率![]()
(2)
1.3.2.3 理化指标
溶解性测定参考郭凌溪[12]报道的方法;湿润性测定参考FOURNAISE等[13]报道的方法;水分含量测定参考GB 5009.236—2016《食品安全国家标准 动植物油脂水分及挥发物的测定》中的第一法;蛋白质含量测定参考GB 5009.5—2016《食品安全国家标准 食品中蛋白质的含量》中的凯氏定氮法;过氧化值(peroxide value,POV)测定参照GB 5009.227—2023《食品安全国家标准 食品中过氧化值的测定》。
1.3.2.4 结构表征
a)热稳定性
使用热重分析仪评估壁材和微胶囊的热稳定性。称取适量样品放入氧化铝杯中,设置热扫描范围为50~500 ℃,设置N2为冲洗气体,流速20 mL/min,升温速率10 ℃/min。
b)XRD光谱
将微胶囊颗粒平铺于样品板中,获得无裂纹的平坦表面。以Cu-Ka射线作为激发源,测定样品的结晶度,电压30 kV,电流20 mA,衍射角范围4°~40°,扫描速度0.2°/min[14]。
c)微观形态
通过显微镜观察文冠果油微胶囊及其乳液微观形态,用共聚焦激光扫描显微镜40倍油镜观察样品,设定激发波长为488 nm,在此条件下观察乳液微观形态。
1.4 数据处理与分析
所有实验均设置3个平行组,结果以“平均值±标准差”表示,采用SPSS 27软件对数据进行方差分析,P<0.05为差异显著。柱状图绘图采用GraphPad Prism 8.0软件,曲线绘图采用Origin 2021软件。
2 结果与分析
2.1 文冠果油微胶囊的包埋性能分析
如图1所示,AS-MD组微胶囊包埋率明显低于SPI-MD组,且不同壁材比例条件下制备的微胶囊包埋率差异较大;SPI-MD组的微胶囊包埋率相对较高,其中SPI-MD 3∶2比例时最高可达77.09%,表明SPI-MD 3∶2微胶囊的包埋效果最好,微胶囊的稳定性和缓释性能更好[15]。高包埋率不仅抑制了次级氧化产物的生成,而且在外界环境和文冠果油之间形成物理屏障,阻碍了文冠果油风味的挥发和释放,进而可以实现文冠果油的高品质保存。

图1 文冠果油微胶囊的包埋率
Fig.1 The embedding rate of Xanthoceras sorbifolium Bunge oil microcapsule
注:不同小写字母代表组间差异显著(P<0.05)(下同)。
2.2 文冠果油微胶囊的理化指标分析
2.2.1 感官评价
如图2所示,文冠果油微胶囊均为正常色泽,且无明显异味,其中AS-MD组微胶囊状态为颗粒状,结构疏松,无结块,少量微胶囊之间互相粘连,可能原因是阿拉伯胶黏度大,颗粒之间存在引力;SPI-MD组微胶囊为粉末状,疏松绵密。由表1可知,5个不同壁材组合制成的文冠果油微胶囊均为乳白色,且无肉眼明显可见的杂质,感官状态良好。
表1 壁材组合对微胶囊的感官评价
Table 1 Sensory evaluation of microcapsules with different proportions of wall materials

壁材色泽、气味、组织状态AS-MD 1∶1乳白色;无味;颗粒状,疏松,无结块,无外来杂质AS-MD 1∶2乳白色;无味;颗粒状,疏松,无结块,无外来杂质AS-MD 1∶3乳白色;无味;颗粒状,疏松,无结块,无外来杂质SPI-MD 3∶1乳白色;无味;粉末状,疏松,结块,无外来杂质SPI-MD 3∶2乳白色;无味;粉末状,疏松,结块,无外来杂质
A-AS-MD1∶1;B-AS-MD1∶2;C-AS-MD1∶3;D-SPI-MD3∶1;E-SPI-MD3∶2
图2 文冠果油微胶囊的宏观形态
Fig.2 Macroscopic morphology of Xanthoceras sorbifolium Bunge oil microcapsule
2.2.2 湿润性
湿润性是指液体湿润固相表明的能力。如图3-A所示,AS-MD组微胶囊湿润性较差,溶解时间较长,可能是由于阿拉伯胶具有较强吸水性,在水中容易吸水溶胀,水化过程需要一定时间所致。而SPI-MD组的微胶囊粉末在水中溶解时间相对较短,总体湿润性优于AS-MD组样品,尤其SPI-MD 3∶2组合时的湿润性最佳。

A-湿润性;B-溶解性;C-水分含量;D-蛋白质含量
图3 文冠果油微胶囊的理化指标
Fig.3 Physical and chemical index of Xanthoceras sorbifolium Bunge oil microcapsule
2.2.3 溶解性
如图3-B所示,SPI-MD组微胶囊的溶解度均高于AS-MD组,这是由于大豆分离蛋白和麦芽糊精易溶于水,良好溶解性使得产品在水中具有较好分散性,油脂被大豆卵磷脂乳化后能更好地被包裹在壁材中。另一方面,SPI-MD 3∶2组微胶囊的溶解性最高,AS-MD的协同效应增加了微胶囊的溶解度,而大豆分离蛋白-麦芽糊精存在亲水性位点[16],对微胶囊的溶解度具有显著影响,表明加入两亲性的大豆分离蛋白能增加微胶囊的溶解度。由于蛋白质分子间氢键的形成,使SPI与水溶性材料MD混合形成的复配壁材的溶解度显著增强[17]。因此,使用SPI-MD作为复合壁材制备得到的微胶囊更易溶于水。
2.2.4 水分含量
水分含量是衡量微胶囊质量的重要性质之一,直接影响微胶囊粉末的贮存稳定性,会对其结晶化产生影响[18]。干燥固体粉末水分含量一般为1%~5%,含量过高会造成囊壁松散,密封度下降,油脂氧化酸败,从而影响货架期内的稳定性和释放性能。如图3-C所示,试验制备的文冠果油微胶囊水分含量较为适中,且SPI-MD组的微胶囊水分含量明显高于AS-MD组合。其中,SPI-MD 3∶1含水率最高,为(4.21%±0.01)%,在干燥过程中水分基本蒸发完全,有利于贮藏。此外,SPI-MD 3∶2组的微胶囊含水率较低,这与EDA等[19]的研究结果相符,因为冷冻干燥升华速率高,水分蒸发较快,使微胶囊干燥较为充分。
2.2.5 蛋白质含量
如图3-D所示,SPI-MD组微胶囊的蛋白质含量均高于AS-MD组,其中SPI-MD 3∶2组微胶囊的蛋白质含量最高为13.98 g/100 g。显然,AS-MD组微胶囊的壁材AS和MD成分构成以多糖为主,蛋白含量较少;而SPI是一种豆类蛋白,蛋白质含量较高,所以SPI-MD 3∶2组微胶囊的蛋白质含量最高。
2.3 文冠果油微胶囊的热稳定性
通过测定样品在升温过程中的质量变化和高温加热过程的逐步降解过程,可评价微胶囊的热稳定性[20]。如图4-A所示,SPI-MD 3∶2质量百分比高于其他组别,表明这一壁材组合制得的微胶囊不仅能保护文冠果油,而且比其他组别的方法更有效。如图4-B所示,文冠果油微胶囊热降解过程大致分为3个阶段:第一阶段的质量损失主要是水分的蒸发和挥发性物质的损失;第二阶段主要是壁材分解,这一阶段前半部分主要分解SPI,后半部分分解MD曲线较平缓,表明SPI-MD组的壁材不易分解,稳定性相对较好;第三阶段质量损失最小,微胶囊最终残留量明显高于文冠果油,表明将文冠果油制成微胶囊具有良好的保护作用。综合3个阶段结果,文冠果油微胶囊在220 ℃之前具有较为稳定的结构,热稳定性较好,适用于食品加工生产。

A-不同比例微胶囊;B-SPI-MD 3∶2微胶囊
图4 文冠果油微胶囊的TGA曲线
Fig.4 TGA curve of Xanthoceras sorbifolium Bunge oil microcapsule
2.4 文冠果油微胶囊的XRD分析
研究表明,当新的包合物形成后不仅晶型发生改变,分子结构也发生改变,从而形成新的物象。通过XRD分析了微胶囊粉末及其壁材和芯材的结晶度。如图5所示,在2θ=20°附近出现了一个宽峰,表明所有样品都处于非晶相,微胶囊衍射峰的出峰位置与单独的SPI和MD基本一致。TAO等[21]用麦芽糖糊精和乳清分离蛋白包埋蓝莓花色苷,通过冷冻干燥的方法制得微胶囊,认为壁材类型不会影响胶囊粉末的结晶度。

A-SPI-MD 3∶2微胶囊与其壁材对比;B-SPI-MD 3∶2微胶囊与原油对比
图5 文冠果油微胶囊的XRD分析
Fig.5 XRD analysis of Xanthoceras sorbifolium Bunge oil microcapsules
2.5 文冠果油微胶囊及其乳液的微观形态
如图6-A显微镜观察结果所示,文冠果油微胶囊的形态为不规则结晶状,边缘颜色较深。如图6-B所示,溶解后的微胶囊乳液边缘颜色较深,中心透明的气泡状物体可能是文冠果油微胶囊的水包油液滴,深色部分明显较厚,推断壁材对文冠果油包埋效果较好,溶于水后缓慢释放所致。如图6-C共聚焦激光扫描显微镜观察结果所示,微胶囊乳液液滴为不规则型,根据油脂在强光下反射出的光线判断,液滴不规则状的原因可能是若干圆形液滴的重合所导致。另一方面,由于冷冻干燥过程中内部失水速度较快,因此微胶囊的表面可能会呈现出凹陷或褶皱。周鑫等[22]通过喷雾干燥制备核桃油微胶囊在表观中同样发现部分微胶囊表面出现褶皱。同时,微胶囊的表面并无破裂或破洞现象,说明壁材起到很好的保护和支撑作用。

A-显微镜10倍观察;B-显微镜40倍观察;C-CLSM观察
图6 SPI-MD 3∶2微胶囊及其乳液形态
Fig.6 SPI-MD 3∶2 microcapsule and its emulsion morphology
2.6 文冠果油微胶囊氧化稳定性分析
POV代表油脂初级氧化产物中氢过氧化物的量,它是反映油脂品质的一项重要指标,POV越低表明油脂品质越好。结果所示,文冠果油的POV[(2.017 8±0.04) mmol/kg]显著高于微胶囊[(0.795 3±0.02)mmol/kg],与未包埋文冠果油相比,文冠果油微胶囊的POV显著降低。壁材阻隔了芯材与外界环境中的氧气、水蒸气接触,提高了油脂的贮藏稳定性,表明微胶囊化过程可显著提升文冠果油的氧化稳定性。因此,通过对文冠果油微胶囊化可避免文冠果油与外界环境直接接触,从而显著降低其氧化速率,保护芯材文冠果油。
3 结论
利用冷冻干燥法制备不同种类壁材组合的文冠果油微胶囊,发现适宜的壁材组合为SPI和MD,二者质量比为3∶2,制备工艺条件为壁材含量83%,芯材成分大豆卵磷脂与文冠果油质量比为2∶15,该条件下制得的微胶囊成型效果好,外形饱满,包埋率达到77%,并具有良好的重现性。文冠果油微胶囊呈乳白色,水分含量较低,溶解度和流动性较好,颗粒完整,表面相对光滑,具有良好的热稳定性和贮藏稳定性,说明微胶囊化能有效抑制或避免文冠果油的氧化变质。
[1] ZHOU Q Y, LIU G S. The embryology of Xanthoceras and its phylogenetic implications[J]. Plant Systematics and Evolution, 2012, 298(2):457-468.
[2] 赵军营, 赵通, 张德, 等. 甘肃省木本油料产业现状及高质量发展对策[J]. 甘肃林业科技, 2023, 48(3):1-7.ZHAO J Y, ZHAO T, ZHANG D, et al. The situation and high quality development proposal on woody oil industry in Gansu province[J]. Journal of Gansu Forestry Science and Technology, 2023, 48(3):1-7.
[3] 陈梓怡. 基于多组学技术揭示文冠果油改善阿尔茨海默症的作用机制[D]. 长春: 吉林大学, 2024.CHEN Z Y. Revealing the mechanism of Xanthoceras sorbifolia bunge oil in improving Alzheimer’s disease based on multiomics technology[D]. Changchun: Jilin University, 2024.
[4] 陆昕,李显玉,杨素芝,等.文冠果种仁营养物质和脂肪酸组成与氨基酸的评价[J].中国粮油学报,2021,36(6):74-80.LU X,LI X Y,YANG S Z,et al.Composition of nutrient substances and fatty acids and evaluation of amino acids in the seed kernel of Xanthoceras sorbifolium bunge[J].Journal of the Chinese Cereals and Oils Association, 2021, 36(6):74-80.
[5] SCHMITT C,TURGEON S L.Protein/polysaccharide complexes and coacervates in food systems[J].Advances in Colloid and Interface Science,2011,167(1-2):63-70.
[6] 张瀛丹,盛良杰,吴澎.微胶囊技术在食品中的应用研究[J].饮料工业,2024,27(2):268-275.ZHANG Y D, SHENG L J, WU P.Research on the application of microcapsule technology in food[J].Beverage Industry, 2024, 27(2):268-275.
[7] GOTTARDO F M, BIDUSKI B, DOS SANTOS L F, et al.Microencapsulated oregano and cinnamon essential oils as a natural alternative to reduce Listeria monocytogenes in Italian salami[J].Food Bioscience,2022,50:102146.
[8] DESPLANQUES S,RENOU F,GRISEL M,et al.Impact of chemical composition of xanthan and acacia gums on the emulsification and stability of oil-in-water emulsions[J].Food Hydrocolloids, 2012,27(2):401-410.
[9] CALVO P,LOZANO M,ESPINOSA-MANSILLA A,et al.In-vitro evaluation of the availability of ϖ-3 and ϖ-6 fatty acids and tocopherols from microencapsulated walnut oil[J].Food Research International,2012,48(1):316-321.
[10] BRILLIANA I N, MANUHARA G J,UTAMI R,et al.The effect of cinnamon bark (Cinnamomum burmanii) essential oil microcapsules on vacuumed ground beef quality[J].IOP Conference Series:Materials Science and Engineering,2017,193:012057.
[11] ZHU J Y, LI X T,LIU L,et al.Preparation of spray-dried soybean oil body microcapsules using maltodextrin:Effects of dextrose equivalence[J].LWT,2022,154:112874.
[12] 郭凌溪. 高载量甘油二酯油微胶囊的构建及其负载姜黄素性质研究[D].无锡:江南大学,2023.GUO L X. Construction of high-load diglyceride oil microcapsules and study on the properties of curcumin loaded on them[D]. Wuxi: Jiangnan University, 2023.
[13] FOURNAISE T, PETIT J,GAIANI C.Main powder physicochemical characteristics influencing their reconstitution behavior[J].Powder Technology,2021,383:65-73.
[14] 张玉荣,倪浩然,吴琼,等.茶树精油微胶囊包埋工艺优化及表征[J].河南工业大学学报(自然科学版),2024,45(5):33-40.ZHANG Y R, NI H R, WU Q,et al.Optimization and characterization of tea tree essential oil microencapsulation[J].Journal of Henan University of Technology (Natural Science Edition),2024,45(5):33-40.
[15] CANO-HIGUITA D M,MALACRIDA C R,TELIS V R N.Stability of curcumin microencapsulated by spray and freeze drying in binary and ternary matrices of maltodextrin, gum Arabic and modified starch[J].Journal of Food Processing and Preservation,2015,39(6):2049-2060.
[16] AKSOYLU ÖZBEK Z, GÜNÇ ERGÖNÜL P.Optimisation of wall material composition of freeze-dried pumpkin seed oil microcapsules:Interaction effects of whey protein, maltodextrin, and gum Arabic by D-optimal mixture design approach[J].Food Hydrocolloids,2020,107:105909.
[17] 王悦. 微藻油微胶囊的制备及其性质研究[D].无锡:江南大学, 2020.WANG Y.Study on preparation and properties of microcapsules of microalgae oil[D].Wuxi:Jiangnan University, 2020.
[18] 鲍杰. 微胶囊化对玫瑰花渣色素理化性质及稳定性的影响研究[D].北京:北京林业大学, 2019.BAO J.Effect of microencapsulation on physicochemical properties and stability of rose residue pigment[D].Beijing:Beijing Forestry University, 2019.
[19] EDA ![]() D,TEMIZ H.Investigation of physicochemical, microstructure and antioxidant properties of firethorn (Pyracantha coccinea var.Lalandi) microcapsules produced by spray-dried and freeze-dried methods[J].South African Journal of Botany,2023,155:340-354.
D,TEMIZ H.Investigation of physicochemical, microstructure and antioxidant properties of firethorn (Pyracantha coccinea var.Lalandi) microcapsules produced by spray-dried and freeze-dried methods[J].South African Journal of Botany,2023,155:340-354.
[20] 杨靖. 高活性水飞蓟油的提取及其微胶囊化研究[D].镇江:江苏大学, 2020.YANG J.Study on extraction and microencapsulation of highly active milk thistle oil [D].Zhenjiang:Jiangsu University, 2020.
[21] TAO Y,WANG P,WANG J D,et al.Combining various wall materials for encapsulation of blueberry anthocyanin extracts:Optimization by artificial neural network and genetic algorithm and a comprehensive analysis of anthocyanin powder properties[J].Powder Technology,2017,311:77-87.
[22] 周鑫, 唐明建, 程一帆, 等. 核桃油微胶囊制备及其氧化稳定性[J]. 现代食品科技, 2025, 41(4):230-238.ZHOU X, TANG M J, CHENG Y F, et al. Preparation and oxidative stability of walnut oil microcapsule[J]. China Industrial Economics, 2025, 41(4):230-238.